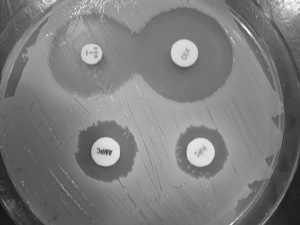

|群馬県・栃木県・茨城県・埼玉県・千葉県・神奈川県・東京都で活動する建築家デザインユニット・一級建築士事務所|
6月11日
本日2つ目の目的地は群馬県前橋市宮城村の家畜診療所。群馬県農業共済組合の獣医さんに施設内を案内してもらいました。
左写真の保存庫の中には右の写真のようなものが入っており、病原菌や細菌にどの抗生物質が有効か検査しているそうです。
他にも薬品庫などを見学させて頂き、現在の改善点や新しく作る場合のポイントなどをお話してもらいました。お忙しい中お時間を取って頂き、本当にありがとうございました。とても勉強になりました!!
本日2つ目の目的地は群馬県前橋市宮城村の家畜診療所。群馬県農業共済組合の獣医さんに施設内を案内してもらいました。
左写真の保存庫の中には右の写真のようなものが入っており、病原菌や細菌にどの抗生物質が有効か検査しているそうです。
他にも薬品庫などを見学させて頂き、現在の改善点や新しく作る場合のポイントなどをお話してもらいました。お忙しい中お時間を取って頂き、本当にありがとうございました。とても勉強になりました!!
ナカザトユウイチ
studioLOOP建築設計事務所
studioLOOP建築設計事務所
コメントする
c a t e g o r y